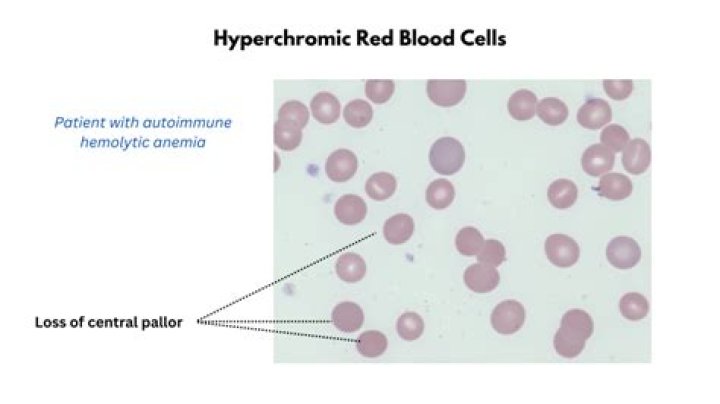
Why is pallor a sign of anemia

Category: Science
What kind of bread is best for you
Sprouted whole grain. Sprouted bread is made from whole grains that have started to sprout from exposure to heat and moisture. … Sourdough. … 100%
Published: Apr 03, 2026
What is Apate the god of
In Greek mythology, Apate (/ˈæpətiː/;Ancient Greek: Απάτη Apátē) was the personification of deceit. Her mother was Nyx, the personification of night. Her
Published: Apr 03, 2026
What is Peachtree drink
Peachtree is the first liqueur that has the taste and smell of tree-ripe peaches, made following a well-balanced recipe and delicate distillation. The taste
Published: Apr 03, 2026
Why is pallor a sign of anemia
Pallor is the most commonly encountered physical finding in patients with anemia. As mentioned earlier, this sign is due to the shunting of blood away from
Published: Apr 03, 2026
What is complete bed bath
A complete bed bath involves washing the entire body. A partial bed bath involves washing the face, hands, underarms and genital/perineal area.
Published: Apr 03, 2026
What is Full Motion TV Mount
A full-motion mount allows you to angle that TV so that you have a great view while laying in bed or while you are getting ready for your day. You can angle
Published: Apr 03, 2026
How did Willowdean get disqualified in dumplin
In the film, Willowdean is disqualified after failing to abide by pageant regulations that allow for final improvements for talent costume and formal wear to
Published: Apr 03, 2026
Can a blood pressure cuff cause nerve damage
]. The incidence of automatic blood pressure cuff-related nerve injury is unknown, as it has been described only in case reports. All of the case reports
Published: Apr 03, 2026